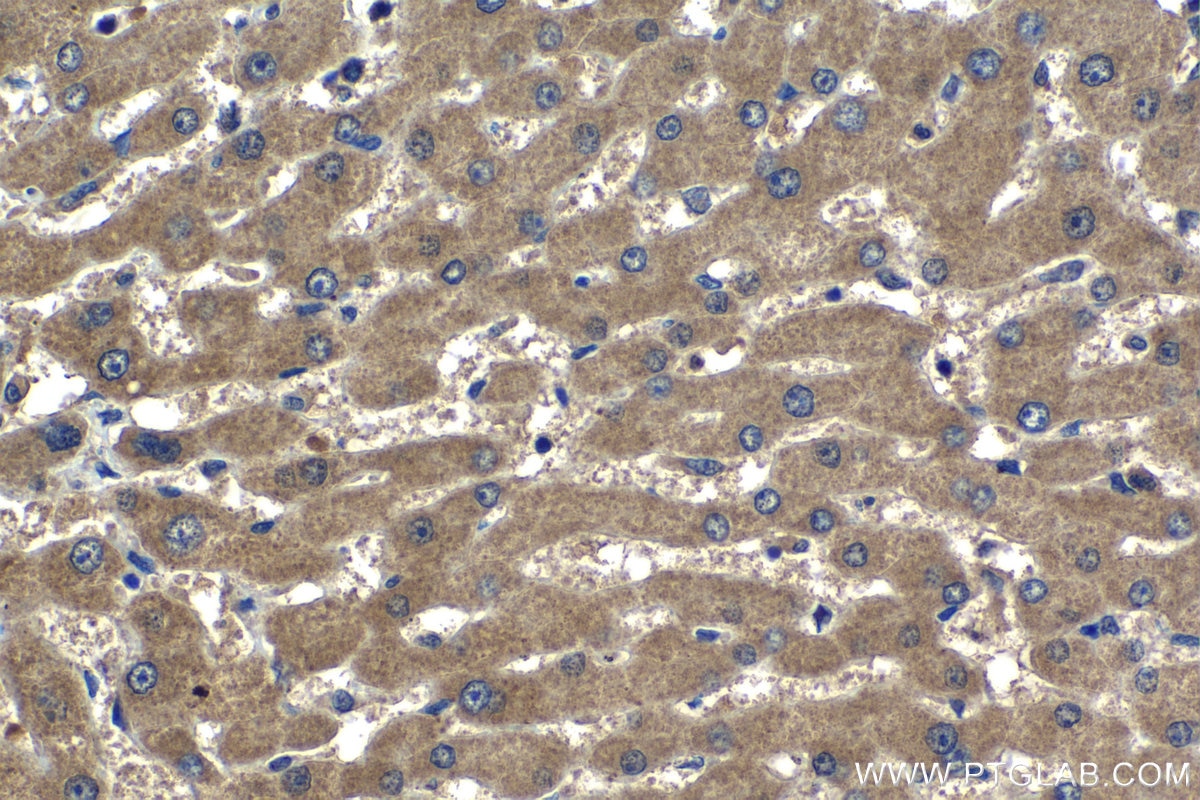
Immunohistochemistry (IHC) staining of human liver tissue using SPDYC Polyclonal antibody (22471-1-AP)
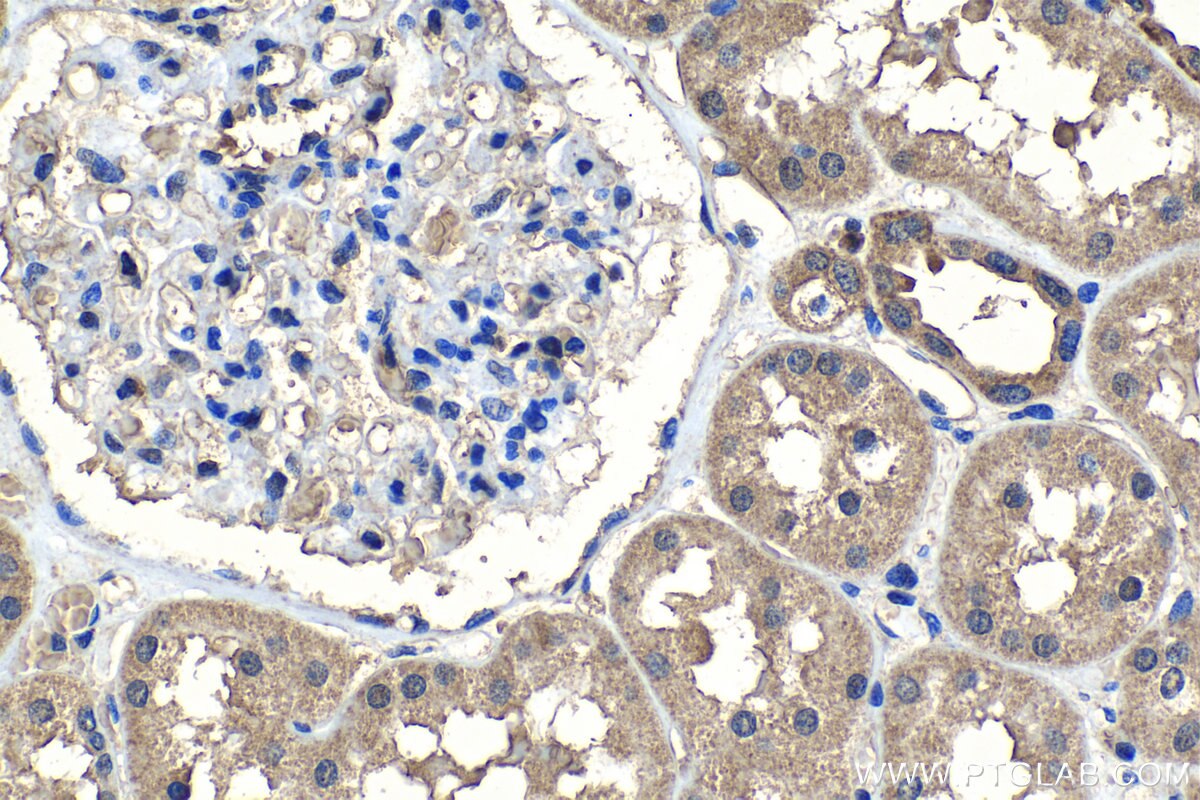
Immunohistochemistry (IHC) staining of human kidney tissue using SPDYC Polyclonal antibody (22471-1-AP)
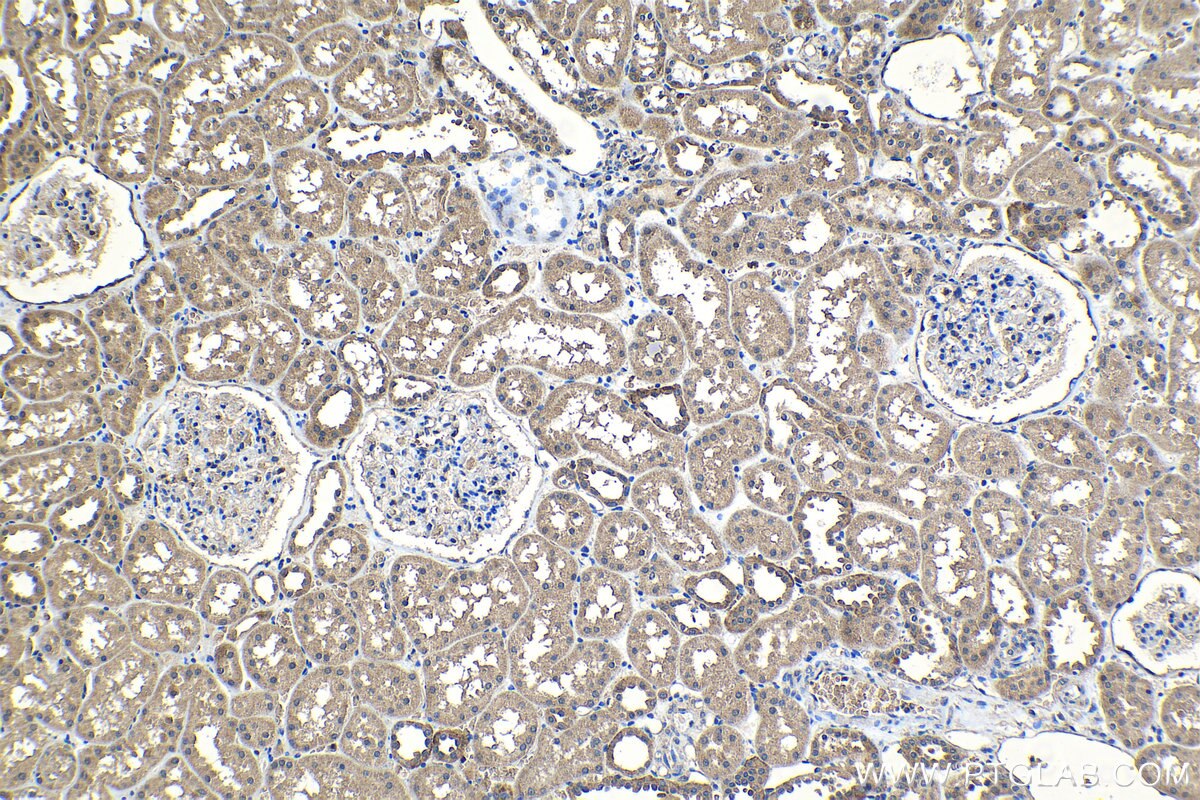
Immunohistochemistry (IHC) staining of human kidney tissue using SPDYC Polyclonal antibody (22471-1-AP)
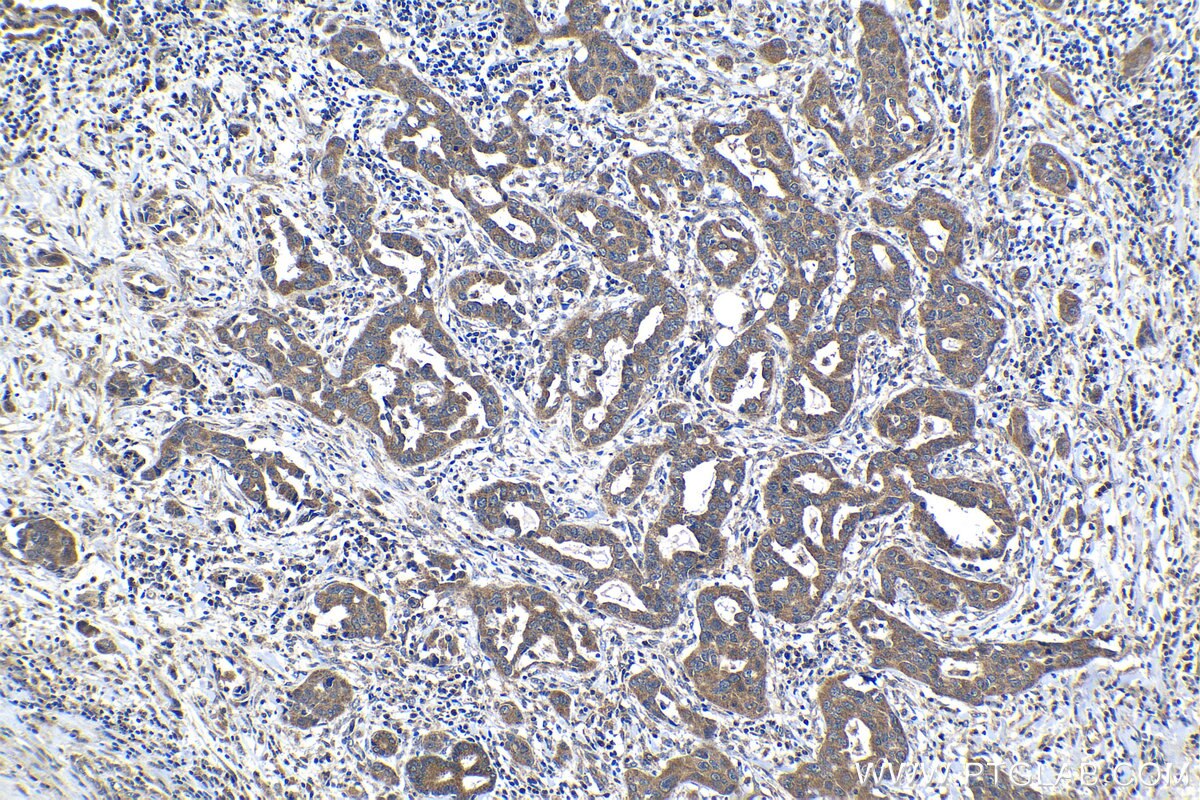
Immunohistochemistry (IHC) staining of human lung cancer tissue using SPDYC Polyclonal antibody (22471-1-AP)

Tested Applications
| Positive IHC detected in | human liver tissue, human kidney tissue, human lung cancer tissue Note: suggested antigen retrieval with TE buffer pH 9.0; (*) Alternatively, antigen retrieval may be performed with citrate buffer pH 6.0 |
Recommended dilution
| Application | Dilution |
|---|---|
| Immunohistochemistry (IHC) | IHC : 1:250-1:1000 |
| It is recommended that this reagent should be titrated in each testing system to obtain optimal results. | |
| Sample-dependent, Check data in validation data gallery. | |
Product Information
22471-1-AP targets SPDYC in IHC, ELISA applications and shows reactivity with human samples.
| Tested Reactivity | human |
| Host / Isotype | Rabbit / IgG |
| Class | Polyclonal |
| Type | Antibody |
| Immunogen |
CatNo: Ag18126 Product name: Recombinant human SPDYC protein Source: e coli.-derived, PGEX-4T Tag: GST Domain: 1-293 aa of BC137244 Sequence: MLWAIPELGSPCPISISYEMSDSQDPTTSPVVTTQVELGGCSRQGGGNGFLRFRQHQEVQAFLSLLEDSFVQEFLSKDPCFQISDKYLLAMVLVYFQRAHLKLSEYTHSSLFLALYLANDMEEDLEGPKCEIFPWALGKDWCLRVGKFLHQRDKLWARMGFRAVVSRQCCEEVMAKEPFHWAWTRDRRPHHGGVQRVCPQVPVRLPRGPGLSPPHCSPCGLPQHCSSHLLKPVSSKCPSLTSECHRPPSQNYLSRVKNAWGGDFLIVLPPQMQLEPGTYSLRIFPKPPARPGH Predict reactive species |
| Full Name | speedy homolog C (Xenopus laevis) |
| Calculated Molecular Weight | 293 aa, 33 kDa |
| Observed Molecular Weight | 33-40 kDa |
| GenBank Accession Number | BC137244 |
| Gene Symbol | SPDYC |
| Gene ID (NCBI) | 387778 |
| RRID | AB_3085699 |
| Conjugate | Unconjugated |
| Form | Liquid |
| Purification Method | Antigen Affinity purified |
| UNIPROT ID | Q5MJ68 |
| Storage Buffer | PBS with 0.02% sodium azide and 50% glycerol, pH 7.3. |
| Storage Conditions | Store at -20°C. Stable for one year after shipment. Aliquoting is unnecessary for -20oC storage. 20ul sizes contain 0.1% BSA. |
Background Information
SPDYC(Speedy protein C), also known as RINGOC and Ringo2, promotes progression through the cell cycle via binding and activation of CDK1 and CDK2. Downregulation of SPDYC inhibits cell growth, reduces the fraction of cells in G1, and increases the S and G2 populations(PMID: 18802405). SPDYC is involved in the spindle-assembly checkpoint and required for recruitment of MAD2L1, BUBR1 and BUB1 to kinetochores(Uniprot).
Protocols
| Product Specific Protocols | |
|---|---|
| IHC protocol for SPDYC antibody 22471-1-AP | Download protocol |
| Standard Protocols | |
|---|---|
| Click here to view our Standard Protocols |